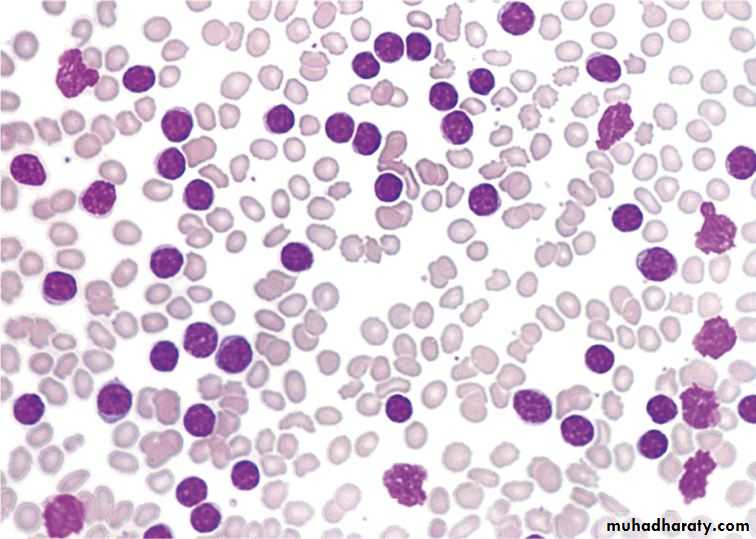

The Chronic Lymphoid Leukaemias
Classification& Diagnosis:These are a group of disorders, characterized by accumulation of mature lymphocytes of either B- or T-cell type in the blood, producing a chronic persistent lymphocytosis.
Subtypes are distinguished by morphology, immunophenotype and cytogenetics. In general, these diseases are incurable but tend to run a chronic and fluctuating course.
1
• Chronic lymphocytic leukaemia:
• Chronic lymphocytic leukaemia (CLL) is the most common with a peak incidence between 60 and 80 years.• Aetiology is unknown.
• It is the most common of the leukaemias in the Western world
• There is an increased risk of CLL in the close relatives of patients which indicates a genetic predisposition.
• The tumour cell appears to be a relatively mature B cell. The cells accumulate in the blood, bone marrow, liver, spleen and lymph nodes as a result of increased production and prolonged lifespan with impaired apoptosis.
• Small lymphocytic lymphoma (SLL) is the tissue equivalent of CLL. The lymphoma cells have the same immunophenotype and cytogenetics but in SLL there is solid tissue disease and fewer than 5 × 109/L circulating monoclonal B cells.
2
• Clinical features:
• 1 - The disease occurs in older subjects with only 15% of cases before 50 years of age. The male: female ratio is 2:1.
• 2 - Most cases are diagnosed when a routine blood test is performed. With increasing routine medical check-ups, this proportion is rising to > 80%.
• 3 - Symmetrical enlargement of cervical, axillary or inguinal lymph nodes is the most frequent clinical sign. The nodes are usually discrete and non-tender. Tonsillar enlargement may be a feature.
• 4 - Features of anaemia may be present. Patients with thrombocytopenia may show bruising or purpura.
• 5 - Splenomegaly and, less commonly, hepatomegaly are common in later stages.
• 6 - Immunosuppression may be a significant problem resulting from hypogammaglobulinaemia and cellular immune dysfunction. Early in the disease course bacterial infections predominate but with advanced disease viral and fungal infections such as herpes zoster are also seen
3
Chronic lymphocytic leukaemia: bilateral cervical lymphadenopathy
• Chronic lymphocytic leukaemia: herpes zoster infection
4• Laboratory findings
• 1 - Lymphocytosis. The absolute clonal B cell lymphocyte count is >5 × 109/L and may be up to 300 × 109/L or more. Between 70 and 99% of white cells in the blood film appear as small lymphocytes. Smudge or smear cells are also present• 2 - Immunophenotyping of the lymphocytes shows them to be B cells (surface CD19+). This is shown to be monoclonal because of expression of only one form of light chain (κ or λ)
• 3 - Normochromic normocytic anaemia is present in later stages as a result of marrow infiltration or hypersplenism. Autoimmune haemolysis may also occur Thrombocytopenia occurs in many patients.
• 4 - Bone marrow aspiration shows lymphocytic replacement of normal marrow elements. Lymphocytes comprise 25—95% of all the cells.
• 5 - Reduced concentrations of serum immunoglobulins are found and this becomes more in advanced disease. Rarely, a paraprotein is present.
• 6 - Autoimmunity directed against cells of the haemopoietic system is common. Autoimmune haemolytic anaemia is most frequent but immune thrombocytopenia, neutropenia and red cell aplasia are also seen.
5
• Chronic lymphocytic leukaemia: peripheral blood film showing lymphocytes with thin rims of cytoplasm, coarse condensed nuclear chromatin and rare nucleoli. Typical smudge cells are present.
6
Immunophenotyping of CLL by flow cytometric cell (FACS) analysis.
The cells are CD5 +, CD19 +, CD20 +, CD23 +, CD79b +, lambda light chain +7
• Prognostic markers
8• Staging:
• It is useful to stage patients at presentation both for prognosis and for deciding on therapy.• Rai and Binet staging systems.
• Typical survival ranged from 12 years for Rai stage 0 to less than 4 years for stage IV but there is considerable variation between patients, and with current therapies survival rates are improving.
• Most patients in Stage O have a normal life expectancy.
9
10
• Treatment
• Cures are rare in CLL and so the approach to therapy is conservative, aiming for symptom control rather than a normal blood count. Indeed, chemotherapy given too early in the disease can shorten rather than prolong life expectancy. Many patients never need treatment. Treatment is given for troublesome organomegaly, haemolytic episodes and bone marrow suppression. The lymphocyte count alone is not a good guide to treatment. Usually, patients in Binet stage C will need treatment as will some in stage B.11
• Chemotherapy
• The optimal treatment for patients with CLL is a combination therapy known as R-FC which combines the antibody rituximab (anti-CD20) with fludarabine and cyclophosphamide. These agents are given together every 4 weeks and are able to control the white cell count, and reduce organ swelling, in most cases. Four to six courses are usually given and treatment can be stopped after a satisfactory response has been achieved. The average 'time to disease progression' after treatment with R-FC is approximately 36 months.• Side effects include myelosuppression and immunosuppression. Purine analogues such as fludarabine lead to a prolonged reduction of CD4 (helper) T lymphocytes and co-trimoxazole is typically given during, and for 6 months after treatment as prophylaxis against Pneumocystis carinii infection. Aciclovir is also given for prophylaxis against herpes infections.
12
• Chlorambucil
• Monoclonal antibodies Rituximab (anti-CD20)• Corticosteroids
• Lenalidomide is a thalidomide derivative
• Other forms of treatment
• •Radiotherapy
• •Combination chemotherapy (R - CHOP) with rituximab in late-stage cases.
• •Bendamustine is both an alkylating agent and purine analogue.
• •Ciclosporin Red cell aplasia.
• •Splenectomy generally reserved for those patients with immune-mediated cytopenias that do not respond to short courses of steroids or those with painful bulky enlargement of the spleen not responding to other therapy.
• •Immunoglobulin replacement Immunoglobulin (e.g. 400mg/kg/month by intravenous infusion) is useful for patients with hypogammaglobulinaemia and recurrent infections, especially during winter months.
• •Stem cell transplantation This is currently an experimental approach in younger patients. Allogeneic stem cell transplantation (SCT) may be curative but has a high mortality rate.
13
• Course of disease
• Many patients in Binet stage A or Rai stage 0 or I never need therapy and this is particularly likely for those with favourable prognostic markers.
• For those who do need treatment a typical pattern is that of a disease that is responsive to several courses of chemotherapy before the gradual onset of extensive bone marrow infiltration, bulky disease and recurrent infection.
• The disease may transform into a localized high-grade lymphoma (Richter's transformation) or there may be the appearance of an increasing number of prolymphocytes that are resistant to treatment.
14